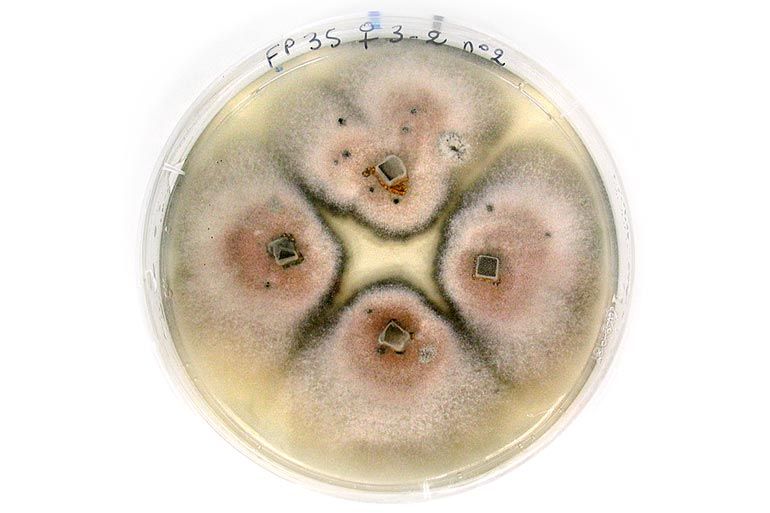
Colletotrichum

Champignon
Colletotrichum
Programmes d'expérimentation en cours
Suivis épidémiologiques
L’acquisition de connaissances sur le cycle du Colletotrichum, ses sources d’inoculum et sa reconnaissance au terrain, les facteurs favorisant ou limitant son développement sont des éléments essentiels pour une gestion durable du pathogène. Les deux espèces majoritaires (C. godetiae et C. fiorinae) sont étudiées afin d’adapter au mieux les pratiques et d’optimiser les méthodes de lutte.
Facteurs de développement et de conservation du champignon
Afin de déterminer les facteurs favorisant la croissance et la germination du champignon, ou encore la quantité de spores présentes sur les organes de conservation, différentes études ont été menées en laboratoire et en verger.
La germination des spores est fortement influencée par la température et la durée d’humectation. La fourchette de températures optimales se trouve entre 25 et 30°C. En dessous de 10°C et au-dessus de 35°C, la germination semble fortement limitée.
Des tests de sensibilité variétale et de stade de maturité ont permis de montrer que Franquette était moins sensible à Colletotrichum, en comparaison à Fernor et Lara qui ont une sensibilité plus importante et similaire.
Les fruits tendent également à être plus sensibles avec l’évolution de la maturité, expliquant les évolutions parfois très rapides de symptômes à l’approche de la récolte.
Le champignon est capable de se conserver en hiver dans les fruits momifiés, les bourgeons et les rameaux, mais ce sont les fruits qui représentent la source d’inoculum primaire la plus importante.
Etude des émissions de spores de Colletotrichum
Le champignon se conserve pendant l’hiver dans les fruits infectés, restant au sol ou sur l’arbre. Au printemps, ils sont des sources de contamination primaire. Des émissions secondaires ont également lieu à partir des fruits contaminés au cours de la saison. Des émissions de spores sont observées à chaque pluie. Les spores émises sont beaucoup plus nombreuses pour la phase secondaire d’émissions.
Suivi des symptômes sur noix et causalité
Les symptômes de Colletotrichum sont difficilement identifiables sur fruits en début de saison (juin). Ils ressemblent à ceux d’autres pathogènes (bactériose du noyer notamment). Les sporulations, caractéristiques de Colletotrichum, apparaissent généralement entre mi-juillet et début août. Les noix avec des symptômes de Colletotrichum présentent également souvent des nécroses apicales de bactériose, mais le champignon est capable d’attaquer un fruit sans porte d’entrée préalable.
Enquête
Une enquête a été effectuée pour étudier les pratiques des nuciculteurs des deux bassins de production ainsi que les conditions pédoclimatiques respectives. Il n’a pas été possible de distinguer des pratiques culturales ou des conditions d’environnement du verger plus favorables au champignon. La présence d’autres bioagresseurs semble accentuer les dégâts dus à Colletotrichum.

Méthodes de lutte
L’objectif est d’apporter des solutions de lutte efficaces et durables pour la profession, que ce soit en lutte chimique ou alternative. Des tests d’efficacité de solutions chimiques et/ou alternatives sont réalisés en boîtes de Pétri, sur fruits détachés et au terrain. Des mesures prophylactiques ont également été évaluées en parcelles.
Evaluation de solutions de lutte au laboratoire
Il n’existe pas à ce jour de molécule homologuée efficace contre Colletotrichum sur noyer.
Il s’agit ici d’évaluer l’efficacité in vitro (sur milieu de culture en boîtes de Pétri) et in vivo (sur fruits détachés) de molécules sur Colletotrichum afin de sélectionner les meilleurs candidats pour des essais au verger.
Evaluation de solutions ou de stratégies de lutte et de positionnements au terrain
L’évaluation de solutions de lutte a pour but de déterminer l’efficacité de différents produits : conventionnels, biologiques, de biocontrôle, substances de base… La plupart de ces substances ont d’abord été testées au laboratoire. Il s’agit dans un premier temps de se confronter au terrain (micro parcelles), puis de les évaluer en vue de leur homologation (grandes parcelles). Certains essais sont des Essais Officiellement Reconnus.
D’autres essais ont pour objectif de valider le positionnement d’un produit, ou de comparer différentes stratégies de traitements dans la lutte contre les anthracnoses du noyer, notamment Colletotrichum.
Prophylaxie
Les essais de prophylaxie hivernale ont pour but d’évaluer l’impact de la réduction de l’inoculum (secouage des fruits momifiés restés dans le canopée, broyage des momies et feuilles au sol) sur les contaminations du printemps de l’année suivante. La fréquence des symptômes et leur sévérité ont baissé au cours des trois années d’essai. Une baisse de pression est observée mais le lien avec les mesures prophylactiques mises en place n’est pas évident. Les tendances montrent tout de même un effet positif des mesures prophylactiques.
Pour la prophylaxie estivale, le but était de voir si certaines mesures prophylactiques utilisées comme moyen de lutte physique (soufflage et broyage des momies) auraient un effet bloquant sur l’évolution de la maladie. Ceci permettrait de sauver la récolte en cours lorsqu’il existe une explosion des symptômes de Colletotrichum durant l’été. Les essais n’ont pas permis de mettre en évidence un apport significatif de ces méthodes.